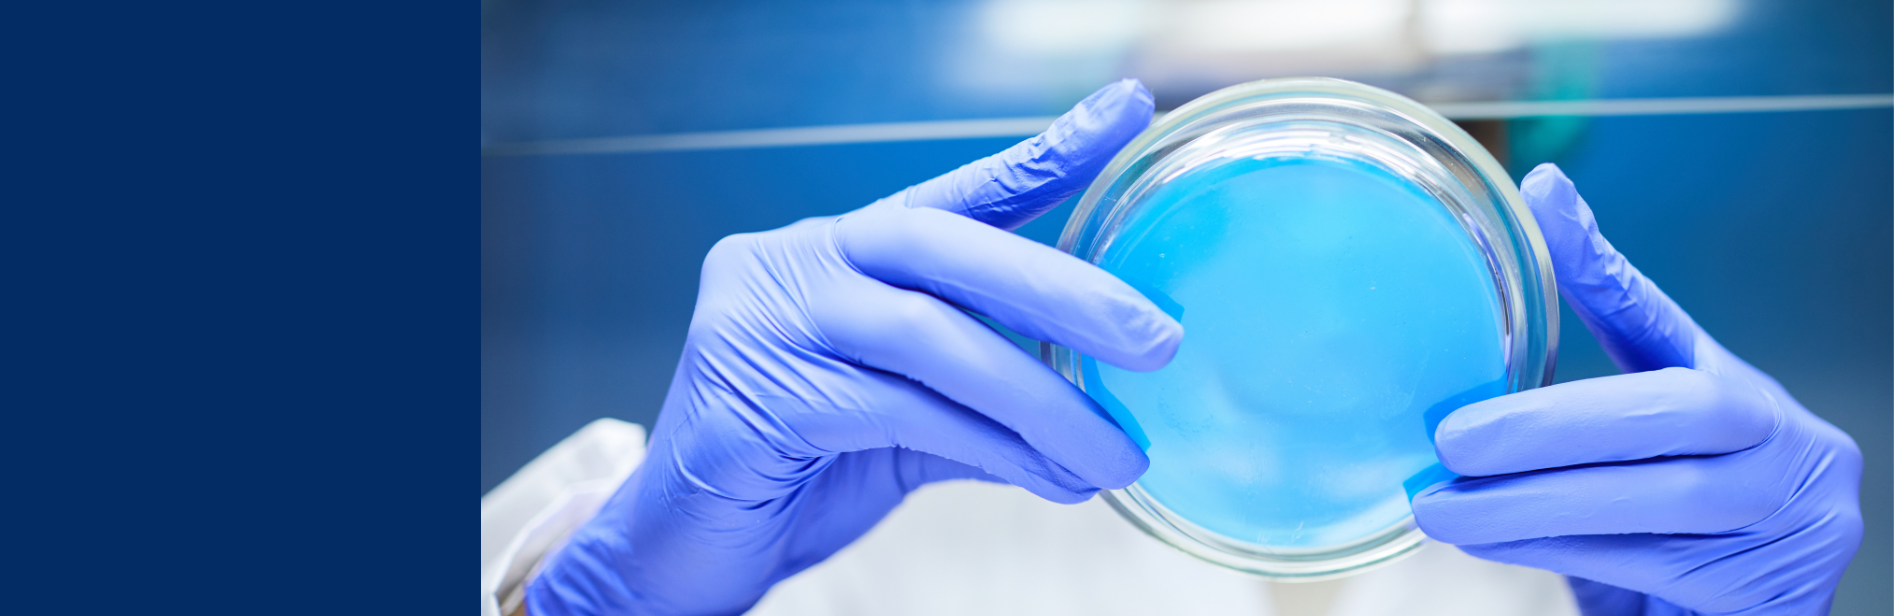
banner-millidrop

Microbiological analyses are important in diverse areas, from medical research, such as antibiotic resistance research, industrial biomanufacturing, and food production in general, to the analysis of soil microbiota in farming and environmental protection efforts. However, standard microbiology testing requires intensive labour, with additional limitations on throughput and reproducibility, making it difficult to generate sufficient statistics.
To address this, MilliDrop, now part of the Gold Standard Diagnostics network, developed a patented technology that offers an automated solution, whereby up to 2,000 biological tests can be simultaneously performed under controlled culture conditions. The innovation can also handle over 750 different conditions in a single experiment. This high-throughput solution revolutionises microbiological screening, which traditionally requires organisms (such as bacteria) to be grown on individual petri dishes.
The technology relies on the generation of droplets of 1 microlitre (one millionth of a litre) in volume, which takes place inside a capillary. The droplets are safely transported in oil, each one separated from the others by a gaseous bubble to prevent them from merging. Biological growth under the specified conditions can then be measured, with a microbial growth curve being produced for each droplet in order to obtain the growth kinetics of the different organisms in different media. At the end of the experiment, droplets of interest can be individually recuperated for further analysis via PCR or genomic sequencing, or for regrowth.
The technology is not only high-throughput, but also excludes the risk of biological contamination during droplet preparation by preventing direct contact between the capillary tip and the solutions inside the well. Moreover, the fact that so many different conditions can be simultaneously tested in one experiment leads to reliable, reproduceable data of high quality.
MilliDrop’s patented technology has been tested with organisms as varied as bacteria, yeast, algae, filamentous fungi, phages and nematodes. Even before its large-scale commercial application, it has already been leveraged by multiple industrial and academic customers in Europe.
The science behind
Instead of using conventional microfluidic chips, MilliDrop has developed a cylindrical fluidic geometry where one-microlitre droplets are produced from conventional well plates, circulated inside transparent plastic capillaries, lubricated with a biocompatible oil that preserves the chemical and biological integrity of the droplets, and separated with gas bubbles (the composition of which can be adjusted) so that it can be used for specific anaerobic applications.
The continuous circulation of the droplets through a series of optical detectors (to measure biological growth by optical density or fluorescence) allows the growth kinetics indicators for each droplet to be acquired.